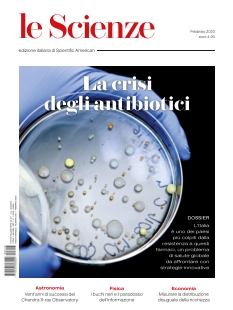

Le Scienze è l'edizione italiana di Scientific American, con articoli su scoperte scientifiche, ricerca e tecnologia. Incluso nell'abbonamento Cafeyn Premium, Le Scienze è ideale per gli appassionati di scienza e innovazione. Abbonati tramite Cafeyn per comprendere i misteri della scienza moderna.
Sfoglia gli archivi di questo titolo

1 lug 2020

1 giu 2020

1 mag 2020

1 apr 2020

1 mar 2020
1 feb 2020

1 gen 2020

1 dic 2019

1 nov 2019

1 ott 2019

1 set 2019

1 ago 2019

1 lug 2019

1 giu 2019

1 mag 2019

1 apr 2019

1 mar 2019

1 feb 2019

2 gen 2019

1 dic 2018

2 nov 2018

2 ott 2018

4 set 2018

31 lug 2018

30 giu 2018

31 mag 2018

2 mag 2018

2 apr 2018

1 mar 2018

1 feb 2018

2 gen 2018

30 nov 2017

31 ott 2017

3 ott 2017

2 set 2017

1 ago 2017

3 lug 2017

31 mag 2017

3 mag 2017

3 apr 2017

1 mar 2017

1 feb 2017

1 gen 2017

1 dic 2016

1 nov 2016

27 set 2016

31 ago 2016

30 lug 2016

30 giu 2016

31 mag 2016

